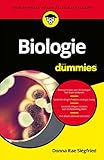

10 libros de Donna Rae Siegfried en orden cronológico
+ Tabla de contenido
Explora la cautivadora cronología de los extraordinarios libros de Donna Rae Siegfried, cuidadosamente clasificados en nuestra biblioteca. Desde los bestsellers de bolsillo hasta los libros electrónicos más recomendados, la lectura de las obras de Donna Rae Siegfried comienza aquí.
Los mejores 10 libros de Donna Rae Siegfried
Busca el próximo título para añadir a tu biblioteca, navegando por nuestra clasificación de los libros de Donna Rae Siegfried por orden cronológico de publicación con el mes y el año, en formato ebook, de bolsillo o tapa blanda.
1. Het menselijk lichaam voor Dummies (Dutch Edition)

- Escrito por Donna Rae Siegfried
- Editorial: Voor Dummies
- 558 páginas
- Publicado en julio 2023
- 4.80/5
2. Physiologie kompakt für Dummies (German Edition)

- Escrito por Donna Rae Siegfried
- Editorial: Wiley-VCH
- 301 páginas
- Publicado en febrero 2022
- 4.90/5
3. Anatomie kompakt für Dummies (German Edition)

- Escrito por Donna Rae Siegfried
- Editorial: Wiley-VCH
- 248 páginas
- Publicado en diciembre 2021
- 4.0/5
4. Anatomie und Physiologie für Dummies (German Edition)

- Escrito por Donna Rae Siegfried
- Editorial: Wiley-VCH
- 391 páginas
- Publicado en marzo 2021
- 4.60/5
5. Biologie voor Dummies (Dutch Edition)
- Escrito por Donna Rae Siegfried
- Editorial: Uitgeverij MUS
- 534 páginas
- Publicado en enero 2018
- 4.30/5
6. Anatomie und Physiologie für Dummies

- Escrito por Donna Rae Siegfried
- Editorial: Wiley-VCH Verlag GmbH
- 456 páginas
- Publicado en agosto 2017
- 4.20/5
7. Anatomie kompakt für Dummies

- Escrito por Donna Rae Siegfried
- Editorial: Wiley-VCH Verlag GmbH
- 233 páginas
- Publicado en julio 2016
- 4.90/5
8. Physiologie für Dummies kompakt

- Escrito por Donna Rae Siegfried
- Editorial: Wiley-VCH Verlag GmbH
- 267 páginas
- Publicado en julio 2016
- 4.80/5
9. Het menselijk lichaam voor dummies

- Escrito por Donna Rae Siegfried
- Editorial: Pearson Benelux
- 332 páginas
- Publicado en marzo 2008
- 4.60/5
10. Biologie Fur Dummies

- Escrito por Donna Rae Siegfried
- Editorial: Wiley-VCH Verlag GmbH
- 368 páginas
- Publicado en octubre 2007
- 4.20/5
10 libros de Donna Rae Siegfried por orden cronológico de publicación
En la bibliografía de Donna Rae Siegfried encuentra los siguientes libros clasificados por fecha de publicación. Elige un bestseller o empieza a leer los libros más bonitos recomendados de la siguiente lista actualizada.
| Nombre | Editorial | Páginas | Fecha |
|---|---|---|---|
| Het menselijk lichaam voor Dummies (Dutch Edition) | Voor Dummies | 558 | 07/2023 |
| Physiologie kompakt für Dummies (German Edition) | Wiley-VCH | 301 | 02/2022 |
| Anatomie kompakt für Dummies (German Edition) | Wiley-VCH | 248 | 12/2021 |
| Anatomie und Physiologie für Dummies (German Edition) | Wiley-VCH | 391 | 03/2021 |
| Biologie voor Dummies (Dutch Edition) | Uitgeverij MUS | 534 | 01/2018 |
| Anatomie und Physiologie für Dummies | Wiley-VCH Verlag GmbH | 456 | 08/2017 |
| Anatomie kompakt für Dummies | Wiley-VCH Verlag GmbH | 233 | 07/2016 |
| Physiologie für Dummies kompakt | Wiley-VCH Verlag GmbH | 267 | 07/2016 |
| Het menselijk lichaam voor dummies | Pearson Benelux | 332 | 03/2008 |
| Biologie Fur Dummies | Wiley-VCH Verlag GmbH | 368 | 10/2007 |
Preguntas sobre los libros de Donna Rae Siegfried
¿Cuál es el último libro de Donna Rae Siegfried?
El último libro publicado por Donna Rae Siegfried se titula Het menselijk lichaam voor Dummies (Dutch Edition) y está a la venta desde julio 2023 por la editorial Voor Dummies en España.
¿Cuál es el primer libro de Donna Rae Siegfried?
El primer libro de Donna Rae Siegfried se remonta a octubre 2007 con el título Biologie Fur Dummies, tiene 368 páginas y fue publicado por la editorial Wiley-VCH Verlag GmbH.
¿Cuántos libros ha publicado Donna Rae Siegfried?
Según nuestras investigaciones, Donna Rae Siegfried ha publicado al menos 10 libros a lo largo de su carrera, sin contar los títulos no encontrados y las ediciones especiales.

